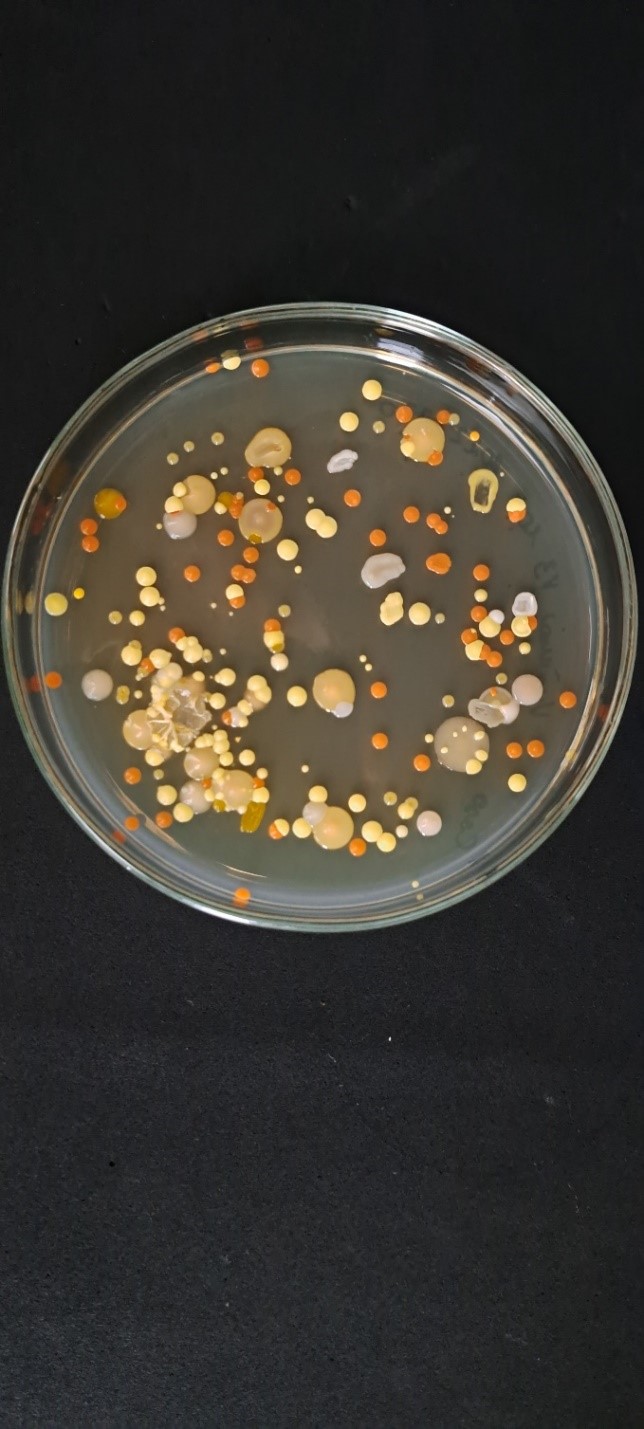
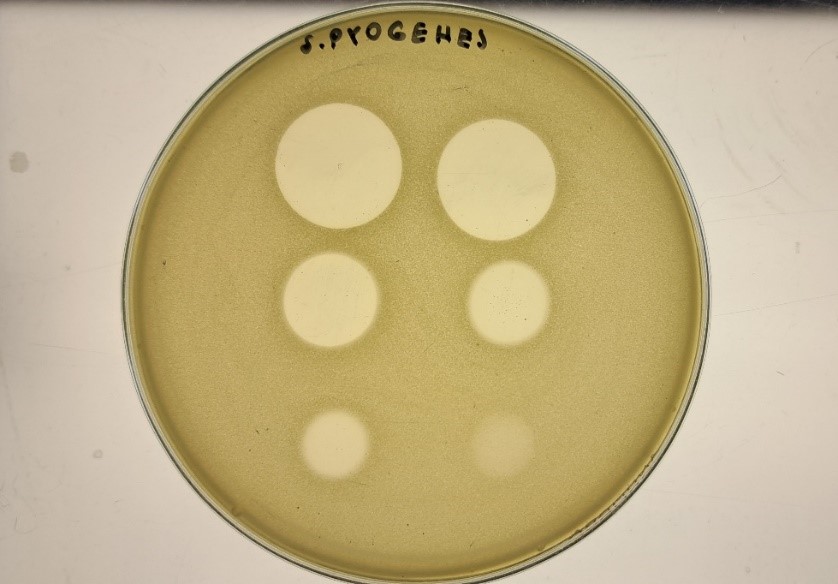

Išmaniosios antimikrobinių medžiagų technologijos – naujos galimybės kovojant su atspariomis infekcijomis (Foto) ()
Plintant antibiotikams atsparioms bakterijoms, vis labiau atsigręžiama į natūralios kilmės bakteriocinus. Šie junginiai gali būti efektyvūs antimikrobinėje terapijoje, taip pakeičiant antibiotikų naudojimą dabartinėje patogenų kontrolėje.
Prisijunk prie technologijos.lt komandos!
Laisvas grafikas, uždarbis, daug įdomių veiklų. Patirtis nebūtina, reikia tik entuziazmo.
Sudomino? Užpildyk šią anketą!
Mikroorganizmų sintetinami bakteriocinai – tai mažos molekulinės masės antibakteriniai peptidai arba baltymai. Juos gamina tiek gramteigiamos, tiek gramneigiamos bakterijos, taip pat archėjos. Šiuo metu žinoma virš 300 skirtingų bakteriocinų, jų įvairovė nuolat didėja ir atrandami nauji veikimo mechanizmai. Vienas plačiausiai ištirtų „gerųjų bakterijų“ sintetinamų bakteriocinų yra nizinas. Jis jau daugelį metų naudojamas maisto pramonėje kaip saugus konservantas, nes slopina pavojingų bakterijų dauginimąsi. Nizinas ardo bakterijų ląstelės sienelę – tarsi praduria mažas skylutes jų apsauginiame apvalkale, dėl to bakterijos praranda gyvybiškai svarbias medžiagas ir žūva.
Mikroorganizmų įvairovė / Ramunės Stanevičienės
Pastaruoju metu tiriama, ar nizinas galėtų būti naudingas ir kovojant su įvairiais žmonių ligų sukėlėjais, tokiais kaip Streptococcus pneumonia, Staphylococus aureus, Salmonella typhimurium ir t. t. Streptococcus pneumonia bakterijos sukelia plaučių ir ausų uždegimą, sinusitą ir net meningitą. Šios bakterijos ypač pavojingos mažiems vaikams, vyresnio amžiaus žmonėms ir silpnesnio imuniteto asmenims.
|
Staphylococus aureus yra vienos dažniausių bakterijų, sukeliančių odos, žaizdų, kraujo ar net plaučių infekcijas. Kai kurios jų padermės, kaip antai antibiotikams atsparus auksinis stafilokokas (MRSA), kelia rimtų gydymo iššūkių. Salmonella typhimurium bakterija dažnai sukelia apsinuodijimą maistu – viduriavimą, pilvo skausmus, karščiavimą.
Tyrimai rodo, kad nizinas sustiprina kai kurių antibiotikų veikimą, kai jie vartojami kartu, arba veiksmingai slopina antibiotikams atsparių bakterijų augimą. Tai reiškia, kad ateityje nizinas galėtų būti naudojamas kaip papildoma priemonė gydant atsparias infekcijas.
Virusinėse dalelėse kapsuliuoto nizino veikimas prieš S. pyogenes bakterijas / Ramunės Stanevičienės nuotrauka
Nepaisant plačiai išvystyto nizino panaudojimo maisto saugai užtikrinti, jo medicininis pritaikymas vis dar yra tyrimų stadijoje. Kaip ir visiems kitiems antimikrobiniams junginiams, būtina įvertinti jo saugumą žmogaus organizme, parinkti tinkamas dozes, nustatyti galimus šalutinius poveikius. Net ir labai veiksminga antimikrobinė medžiaga gali nesuveikti, jei ji suyra per anksti arba nepasiekia infekcijos vietos. Todėl šiuolaikiniai tyrimai vis daugiau dėmesio skiria ne tik junginių, tinkamų naudoti kovai su mikrobais paieškai, bet ir tų junginių apsaugojimui bei tiksliam pristatymui į infekcijos vietą.
Baltyminės kilmės bakteriocinas nizinas yra jautrus aplinkos poveikiui – aukštesnei temperatūrai, šviesai, deguoniui, netinkamam rūgštingumui, organizmo fermentams. Todėl siekiant stabilizuoti ir apsaugoti niziną nuo suirimo bei pratęsti jo veiksmingumą, pasitelkiami įvairūs technologiniai sprendimai. Vienas iš dažniausiai naudojamų stabilizavimo būdų yra įkapsuliavimas, kai veiklioji medžiaga patalpinama į labai mažus darinius - mikrokapsules. Šios apsaugo niziną nuo išorinių veiksnių ir leidžia medžiagai išsiskirti palaipsniui.
Net ir puikiai stabilizuota medžiaga turi dar vieną iššūkį – sėkmingas infekcijos vietos pasiekimas. Organizme jautrią veikliąją medžiagą gali greitai pašalinti kraujotaka, suskaidyti fermentai arba ji gali paveikti ir sveikus audinius, taip sukeldama šalutinį poveikį. Čia į pagalbą ateina pažangios pernašos sistemos – technologijos, leidžiančios tiksliai nukreipti vaistą ten, kur jo reikia. Viena perspektyviausių tokių sistemų yra į virusus panašios dalelės. Jos sudaro apsauginį apvalkalą bakteriocinui bei leidžia kontroliuoti jo atpalaidavimą. Atlikus virusinių dalelių bioinžineriją, modifikavus jų paviršiaus baltymus, galima sukurti išmanias pernašos sistemas, kurios nukreiptų bioaktyvią medžiagą tiksliai į taikinio ląsteles organizme.
Vilniaus universiteto Gyvybės mokslų centro ir VMTI Gamtos tyrimų centro mokslininkai, vykdydami Lietuvos Mokslo Tarybos finansuojamą projektą „Palengvintos bioaktyvių junginių pernašos sistema universaliam biomedicininiam pritaikymui“, Saccharomyces cerevisiae mielių virusinių dalelių pagrindu sukūrė efektyvią ir saugią žmonėms bioaktyvių junginių pernašos sistemą. Buvo nustatytas į mielių virusines daleles supakuoto bakteriocino - nizino veiksmingumas naikinant odos, virškinamojo trakto, kvėpavimo takų ir kitų infekcijų potencialius sukėlėjus. Veikiant bioaktyviomis virusinėmis dalelėmis, buvo sunaikinta virš 99,99% Streptococcus pyogenes ir Staphylococus aureus bakterijų, o atsparesnių, papildomą išorinę apsauginę membraną turinčių gramneigiamų bakterijų Salmonella typhimurium gyvybingumas sumažėjo iki 90%.
Gauti duomenys demonstruoja mielių virusinių dalelių potencialą bioaktyvių medžiagų pernašai ir pritaikomumui medicinoje. Nors nizinas dar nėra įprastas vaistas žmonėms gydyti, tačiau tyrimai rodo daug žadančias perspektyvas ateityje kuriant naujas, saugesnes antimikrobines priemones, leidžiančias kovoti su atspariomis infekcijomis. O su žmogaus organizmu suderinamų „protingų“ bionanodalelių vystymas atveria naujus horizontus bioinžinerijoje ir medicinoje.
Autorė prof. Elena Servienė